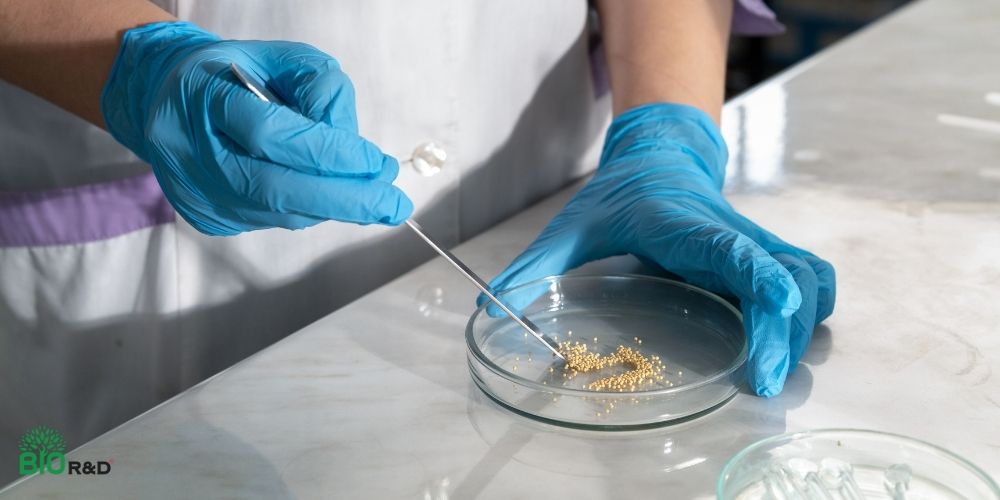
Ứng dụng công nghệ vi sinh vật

Ứng dụng công nghệ vi sinh trong sản xuất nông nghiệp đang trở thành xu hướng giúp nâng cao hiệu quả sản xuất và bảo vệ môi trường. BIO R&D sẽ giúp bạn hiểu rõ khái niệm, lợi ích và ứng dụng thực tế của công nghệ vi sinh trong chăn nuôi sạch, an toàn và bền vững. Hãy cùng tìm hiểu nhé!

Vi sinh vật là gì
Vi sinh vật, bao gồm vi khuẩn, nấm, vi khuẩn cổ (archaea) và virus, tồn tại trong đất với số lượng vô cùng lớn. Những sinh vật siêu nhỏ này tạo thành các quần thể phức tạp gọi là hệ vi sinh vật đất, đóng vai trò then chốt trong chu trình dinh dưỡng, duy trì cấu trúc đất và các mối tương tác giữa cây trồng và vi sinh vật. Các vi sinh vật có lợi giúp cây hấp thu dinh dưỡng tốt hơn, hạn chế bệnh hại và tăng khả năng chống chọi trước khí hậu.
Tuy nhiên, các biện pháp canh tác truyền thống như sử dụng phân bón hóa học, thuốc bảo vệ thực vật và cày xới quá mức thường làm mất cân bằng hệ vi sinh vật đất, dẫn đến thoái hóa đất, rửa trôi dinh dưỡng và giảm khả năng chống chịu của cây trồng.
Khái niệm công nghệ vi sinh
Công nghệ vi sinh là sử dụng các vi sinh vật để thực hiện những chức năng cụ thể. Các vi sinh vật này có thể tồn tại tự nhiên hoặc được biến đổi gen nhằm nâng cao khả năng hoạt động. Công nghệ vi sinh khai thác các quá trình sinh học như lên men, phân hủy sinh học và xử lý sinh học (bioremediation) để tạo ra sản phẩm có giá trị và giải quyết các vấn đề môi trường.
Công nghệ vi sinh trong nông nghiệp khai thác mối quan hệ có lợi giữa vi sinh vật và cây trồng, trong đó vi khuẩn cố định đạm như Rhizobium, Azotobacter giúp giảm nhu cầu phân đạm hóa học, nấm rễ cộng sinh tăng khả năng hấp thu nước và dinh dưỡng, còn các vi sinh vật đối kháng như Trichoderma và Bacillus góp phần ức chế mầm bệnh, bảo vệ cây trồng theo hướng bền vững.
Trong chăn nuôi, công nghệ vi sinh được ứng dụng thông qua việc bổ sung các vi sinh vật có lợi như Lactobacillus, Bacillus và Saccharomyces vào thức ăn hoặc môi trường sống của vật nuôi. Các vi sinh vật này cân bằng hệ vi sinh đường ruột, hỗ trợ hệ tiêu hóa, nâng cao sức khỏe và hiệu quả tăng trưởng của vật nuôi. Vi sinh có lợi cạnh tranh và ức chế vi khuẩn gây bệnh, giảm tỷ lệ mắc bệnh và hạn chế sử dụng kháng sinh. Các chế phẩm vi sinh xử lý chất thải chăn nuôi giúp phân hủy phân và nước thải, giảm mùi hôi và khí thải độc hại như amoniac, tái tạo năng lượng sinh học (biogas).
Các quy trình vi sinh thường bền vững hơn so với phương pháp hóa học. Chúng tiêu tốn ít năng lượng hơn, tạo ra ít chất ô nhiễm hơn và có thể được điều chỉnh linh hoạt theo từng nhu cầu cụ thể. Nhờ tính đa dạng này, công nghệ vi sinh đóng vai trò then chốt trong các ngành đang hướng tới những giải pháp xanh và thân thiện với môi trường.
Vai trò của công nghệ vi sinh đối với nông nghiệp bền vững
Đối với trồng trọt
Cải thiện chất lượng đất canh tác
- Công nghệ vi sinh giúp phục hồi và cân bằng hệ vi sinh vật có lợi trong đất, thúc đẩy quá trình phân giải chất hữu cơ và hình thành mùn.
- Đất trở nên tơi xốp, giàu dinh dưỡng hơn và có khả năng giữ nước, giữ chất tốt hơn, tạo điều kiện thuận lợi cho cây trồng phát triển bền vững.
Hỗ trợ cung cấp và chuyển hóa dinh dưỡng cho cây trồng
- Một số vi sinh vật có khả năng cố định khí nitơ trong không khí, hòa tan lân và kali trong đất thành dạng cây dễ hấp thu.
- Quá trình này giúp cây trồng tiếp cận nguồn dinh dưỡng tự nhiên hiệu quả hơn, giảm thất thoát và nâng cao hiệu suất sử dụng dinh dưỡng.
Giảm phụ thuộc vào phân bón hóa học
- Việc ứng dụng chế phẩm vi sinh giúp giảm nhu cầu sử dụng phân bón vô cơ trong canh tác.
- Tiết kiệm chi phí sản xuất mà còn hạn chế hiện tượng thoái hóa đất và ô nhiễm môi trường do lạm dụng phân bón hóa học.
Tăng sức đề kháng và khả năng chống chịu của cây trồng
Hệ vi sinh vật có lợi trong đất góp phần ức chế mầm bệnh, tăng cường sức khỏe bộ rễ và khả năng chống chịu của cây trước điều kiện bất lợi như hạn hán, ngập úng hoặc sâu bệnh.

Đối với chăn nuôi
Giảm ô nhiễm môi trường
- Các chế phẩm vi sinh được sử dụng để phân hủy chất thải chăn nuôi thành các dạng hữu ích như phân bón hữu cơ, giảm thiểu lượng khí thải gây hiệu ứng nhà kính như metan và amoniac.
- Hệ thống khép kín ngăn chặn nước thải và khí thải ô nhiễm thoát ra ngoài, bảo vệ nguồn nước và không khí xung quanh.
Nâng cao chất lượng sản phẩm
- Công nghệ vi sinh giúp cải thiện sức khỏe vật nuôi bằng cách cân bằng hệ vi sinh đường ruột, tăng cường miễn dịch, và giảm tỷ lệ mắc bệnh.
- Sản phẩm chăn nuôi như thịt, trứng, sữa đạt tiêu chuẩn an toàn, không chứa dư lượng kháng sinh và hóa chất, đáp ứng nhu cầu thực phẩm sạch của thị trường.
Tiết kiệm chi phí
- Việc tái sử dụng chất thải làm phân bón hữu cơ giúp giảm chi phí mua phân bón hóa học.
- Hệ thống khép kín giảm nhu cầu sử dụng nước và năng lượng, tiết kiệm tài nguyên.
Kiểm soát dịch bệnh hiệu quả
- Vi sinh vật có lợi cạnh tranh với vi khuẩn gây bệnh trong môi trường chăn nuôi, giúp giảm nguy cơ bùng phát dịch bệnh.
- Hệ thống khép kín cô lập mầm bệnh, hạn chế sự lây lan ra môi trường bên ngoài.

Cách thức hoạt động của công nghệ vi sinh
Để hiểu rõ vì sao công nghệ vi sinh có thể mang lại hiệu quả bền vững trong nông nghiệp, BIO R&D giới thiệu cách thức hoạt động của công nghệ vi sinh vật, cụ thể như sau:
- Lựa chọn vi sinh vật: Xác định hoặc thiết kế các chủng vi sinh phù hợp với mục đích sử dụng, chẳng hạ như vi khuẩn để phân hủy chất thải hoặc nấm để sản xuất enzyme.
- Chuẩn bị & nuôi cấy: Nuôi trồng vi sinh vật trong môi trường được kiểm soát nhằm đạt sinh khối và mức độ hoạt tính cao.
- Ứng dụng: Đưa vi sinh vật vào môi trường đất, nước hoặc hệ thống công nghiệp.
- Giám sát và tối ưu: Theo dõi hoạt động của vi sinh vật và điều chỉnh các điều kiện như pH, nhiệt độ hoặc chất dinh dưỡng để đạt hiệu quả tối đa.
- Thu hoạch sản phẩm hoặc đánh giá tác động môi trường: Thu nhận các sản phẩm tạo ra (enzyme, nhiên liệu sinh học) hoặc đánh giá cải thiện môi trường như giảm ô nhiễm.
Cách tiếp cận theo từng bước này giúp đảm bảo các giải pháp vi sinh hiệu quả, an toàn và phù hợp với từng nhu cầu cụ thể.
Thách thức khi áp dụng công nghệ vi sinh trong nông nghiệp
Dù mang lại nhiều lợi ích cho nông nghiệp bền vững, việc ứng dụng công nghệ vi sinh trong thực tế vẫn đối mặt với những thách thức sau
- Hiệu quả phụ thuộc nhiều vào điều kiện môi trường như nhiệt độ, độ ẩm, pH đất hoặc môi trường chăn nuôi
- Cần áp dụng đúng kỹ thuật, nếu sử dụng sai có thể làm vi sinh hoạt động kém, không đạt hiệu quả mong muốn
- Trong chăn nuôi, dùng chế phẩm vi sinh kém chất lượng có thể gây rối loạn tiêu hóa cho vật nuôi, làm giảm hiệu quả phòng bệnh
- Chi phí đầu tư ban đầu cho sản phẩm vi sinh chất lượng cao có thể cao hơn phương pháp truyền thống
- Cần thời gian để vi sinh vật phát huy tác dụng, không cho kết quả tức thì

Checklist cho người mua giải pháp công nghệ vi sinh
Để công nghệ vi sinh phát huy hiệu quả và tránh rủi ro trong quá trình sử dụng, nông dân cần cân nhắc kỹ lưỡng các tiêu chí quan trọng trước khi lựa chọn sản phẩm hoặc giải pháp phù hợp. Dưới đây là checklist tham khảo:
- Mức độ phù hợp ứng dụng: Đảm bảo giải pháp vi sinh đáp ứng đúng nhu cầu, dù là xử lý môi trường, sản xuất hay cải tiến quy trình.
- Nguồn gốc chủng vi sinh: Xác minh độ an toàn, hiệu quả và tình trạng phê duyệt pháp lý của các chủng vi sinh.
- Khả năng mở rộng: Đảm bảo giải pháp có thể mở rộng từ quy mô thử nghiệm lên sản xuất lớn mà không giảm hiệu quả.
- Tác động môi trường: Đánh giá dấu chân sinh thái và lợi ích bền vững của giải pháp vi sinh.
- Tuân thủ pháp lý: Kiểm tra việc đáp ứng các tiêu chuẩn an toàn và bảo vệ môi trường trong nước và quốc tế.
- Hỗ trợ & chuyên môn: Ưu tiên nhà cung cấp có hỗ trợ kỹ thuật, khả năng tùy chỉnh và dịch vụ giám sát lâu dài.
- Chi phí & hiệu quả đầu tư (ROI): So sánh tổng chi phí triển khai với lợi ích và hiệu suất mang lại.
Kết luận
Công nghệ vi sinh với những đặc tính đa dạng đang ngày càng khẳng định vai trò quan trọng trong sản xuất nông nghiệp hiện đại, đặc biệt trong cải tạo đất, nâng cao năng suất và giảm phụ thuộc vào hóa chất. Khi được khai thác đúng cách và quản lý rủi ro khoa học, vi sinh vật trở thành nền tảng thúc đẩy đổi mới và phát triển nông nghiệp bền vững. Trên cơ sở đó, BIO R&D là doanh nghiệp ứng dụng công nghệ vi sinh vào nghiên cứu và phát triển các giải pháp nông nghiệp thực tiễn, nhằm hỗ trợ nông dân canh tác hiệu quả hơn, an toàn hơn và góp phần nâng cao chất lượng cuộc sống lâu dài.
Thông tin liên hệ
CÔNG TY TNHH BIO R&D
![]()
- Văn phòng: 83 Xô Viết Nghệ Tĩnh, Phường 7, Thành phố Đà Lạt, Tỉnh Lâm Đồng
- Trang trại: Thôn Thanh Hà, Xã Phi Tô, Huyện Lâm Hà, Tỉnh Lâm Đồng
- Hotline: 0398 411 868 - 0983 276 527
- Website: bior-d.com
- Email: biogap.org@gmail.com